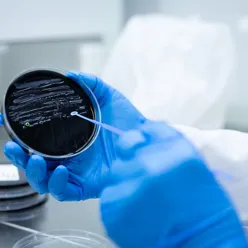
legionella agar skål

Nasjonalt referanselaboratorium for Legionella
Som nasjonalt referanselaboratorium for Legionella bistår vi med diagnostikk, karakterisering og utbrudds- eller smitteoppklaring.
Avdeling for medisinsk mikrobiologi ved Stavanger universitetssykehus har hatt delt nasjonal referansefunksjon for Legionella sammen med Folkehelseinstituttet siden 31.12.2005. Fra 01.08.2021 har avdelingen hele ansvaret for nasjonal referansefunksjon for Legionella.
Nyhet! Har du en pasientprøve fra nedre luftveier med påvist L. pneumophila DNA, men som er dyrkningsnegativ? Til hjelp i smittesporing og utbruddsoppklaring tilbys nå sekvensbasert typing direkte fra prøvematerialet.
Nyhet! Forbedret Legionella urin antigen (LAG) test. De fleste standard LAG tester påviser kun L. pneumophila sg 1. For pasienter med sterk mistanke om/eller påvist Legionella pneumoni men som har negativ L. pneumophila sg 1 LAG test tilbyr vi en LAG test som kan påvise L. pneumophila sg 1-15 og L. longbeachae i urin. se også «Referansediagnostikk og karakterisering»
Utvidet Legionella spp PCR. Ved påvist Legionella species DNA oppfordres det til å sende inn prøvematerialet for utvidet PCR analyse spesifikk for et utvalg klinisk relevante Legionella (non-pneumophila) species (L.micdadei, L.longbeachae, L.bozemanae og L.anisa).
Karakterisering av isolat fra miljøprøver – Miljølaboratorier som ønsker å få artsbestemt eller sekvenstypet legionella-isolat fra miljøprøver som ikke er forbundet med smittesporing kan nå bestille disse analysene hos oss. For informasjon om pris og innsending av prøver, se punkt for miljøprøver under innsending av prøvemateriale.
Mikrobiologiske laboratorier skal sende inn
- Isolat fra pasienter
- Isolat fra vann- og miljøprøver i forbindelse med smitteoppsporing rundt kliniske tilfeller
Mikrobiologiske laboratorier oppfordres til å sende inn
- Prøvemateriale fra nedre luftveier (evt. eluat) fra pasienter med påvist Legionella species DNA for utvidet species PCR. Merk rekvisisjonen med «L.spp DNA påvist, ønsker utvidet PCR»
- Dyrkningsnegativt prøvemateriale fra nedre luftveier fra pasienter med påvist Legionella pneumophila DNA for sekvensbasert typing direkte fra prøvematerialet. Merk rekvisisjonen med “Ønsker SBT fra prøvemateriale»
- Urinprøver fra pasienter med sterk mistanke om/eller påvist Legionella pneumoni men med negativ Legionella pneumophila sg 1 Legionella urin antigen test. Merk rekvisisjonen med: «Sterk mistanke om Legionella-pneumoni, Negativ LAG L.pn sg 1»
- Serumprøver fra personer som har testet positivt for legionella ved PCR og/eller dyrkning. Husk å krysse av for antistoffpåvisning på rekvisisjonen og merk gjerne med «til biobank»
- Legionellapositivt prøvemateriale til lagring i Nasjonal biobank til bruk i metodeutvikling. Merk rekvisisjonen med «til lagring i biobank»
Mikrobiologiske laboratorier kan etter avtale sende inn:
- Prøvemateriale fra nedre luftveier for bekreftende PCR. Merk rekvisisjonen med: «Ønsker bekreftende PCR» samt resultater fra egen PCR
- Prøver fra pasienter med positiv Legionella urinantigentest og/eller positiv Legionella PCR for dyrkning. Merk rekvisisjonen med: «Ønsker dyrkning» samt resultat fra eget laboratorium»
- Prøver fra pasienter med alvorlig pneumoni for primærdiagnostikk. Merk rekvisisjonen med ønsket analyse
- Prøver fra pasienter med alvorlig pneumoni etter opphold i utlandet. Merk rekvisisjonen med ønsket analyse
Rekvisisjon fylles helst ut elektronisk, skrives ut, og sendes sammen med isolatet/prøvematerialet.
Det er viktig at relevant informasjon fra rekvirent når frem til oss, spesielt i forbindelse med smittesporing. Dette fylles inn i rekvisisjonen (se lenke over). Det er en fordel om kopi av primærrekvisisjon i tillegg legges ved.
Dersom vi skal utføre primærdiagnostikk er det viktig at dette oppgis i rekvisisjonen pga svartid.
Analyse av vann- og miljøprøver i forbindelse med smittesporing
Referanselaboratoriet utfører per nå ikke selv primærdiagnostikk av vann- og miljøprøver ved utredning av smittekilde. Slike prøver sendes til egnet miljølaboratorium for analyse.
Innsending av legionella-isolat fra miljøprøver som ikke er forbundet med smittesporing
Rekvisisjon fylles helst ut elektronisk, skrives ut, og sendes sammen med isolatet.
Under seksjon for Prøvemateriale krysses det av for kategori "Tilsendt bakterieisolat" . Under Pasient legges det inn miljølaboratoriets eget prøvenummer og eventuelt informasjon om hvor prøven er tatt (adresse, romnummer, type prøvepunkt osv). Under Kliniske opplysninger/problemstilling legges det inn informasjon om resultat fra egne analyser og hvilken type analyse man ønsker å få gjennomført.
Gjeldende analysepriser
- Legionella artsbestemmelse (Maldi-TOF): 100 kr (eks. moms)
- Sekvensbasert typing av L. pneumophila (helgenomsekvensering): 1700 kr (eks. moms).
- Referansediagnostikk
- Tilby ulike metoder for påvisning og typing av legionella til bruk i diagnostikk, smittesporing og forskning
- Opprettholde nasjonal stammebank over pasientrelaterte legionella-isolat og annet referansemateriale
- Overvåkning, beredskap og respons ved utbrudd av legionellose.
- Vitenskapelig råd og støtte
- Samarbeid og forskning
Primærdiagnostiske analyser, med unntak av legionella-antistoff, er i hovedsak for pasienter ved Stavanger Universitets sjukehus (SUS). I tilfeller hvor lokale sykehuslaboratorier ikke utfører egen legionelladiagnostikk, sendes prøve fortrinnsvis til nærmeste laboratorium som utfører slik diagnostikk. Referanselaboratoriet kan også være behjelpelige med slike analyser, men da etter avtale.
Ved Avdeling for Medisinsk Mikrobiologi (AMM) utføres følgende analyser for påvisning av Legionella direkte fra prøvemateriale:
Legionella-antigen
Ved mistanke om akutt legionella-infeksjon skal urin undersøkes for legionella-antigen. Urinantigentesten påviser Legionella pneumophila serogruppe 1-15 og Legionella longbeachae, og ved milde infeksjoner kan testen gi negativt resultat. Positive prøver analyserer videre på annen test for påvisning av L. pneumophila serogruppe 1.
Legionella PCR
Legionella PCR (A)Ved positiv Legionella-antigen test eller mistanke om akutt legionella-infeksjon undersøkes prøver fra nedre luftveier (bronkialskyllevæske, indusert sputum, trakealsekret og lungevev) undersøkes for legionella-spesifikt DNA ved real-time PCR i de tilfellene hvor vi er primærlaboratorium. Prøver fra øvre luftveier er ikke egnet. I prøvemateriale hvor det er påvist Legionella species utføres utvidet species PCR-analyse spesifikk for et utvalg klinisk relevante Legionella (non-pneumophila) species (L. micdadei, L. longbeachae, L. bozemanae og L. anisa). PCR-positive prøver dyrkes. I tilfeller hvor L. pneumophila PCR-positiv prøve er dyrkningsnegativ vil sekvensbasert typing (SBT) direkte fra prøvematerialet bli vurdert.
Bakteriologisk dyrkning
Legionella, bakteriologisk dyrkning (A)Dyrkning direkte fra prøvematerialet er viktig for å kunne påvise alle legionella-arter. Legionellaisolater karakteriseres gjennom artsidentifisering med Maldi-TOF og agglutinasjon. L. pneumophila types videre gjennom sekvensbasert typing (SBT) fra helgenomsekvens. Isolering av bakterien ved dyrkning er også viktig for oppklaring av eventuelt utbrudd.
Legionella-antistoff
Legionella-antistoffLegionella-antistoff påvisning er hovedsakelig aktuelt som del av en epidemiologisk undersøkelse i forbindelse med utbrudd. Serologi er lite nyttig i akuttfasen og bør alltid baseres på titerstigning i serumpar. Diagnosen Pontiac feber kan stilles serologisk, men dette er mest aktuelt i forbindelse med epidemiologisk undersøkelse ved utbrudd.
Som en del av referansefunksjon i medisinsk mikrobiologi for Legionella kan laboratorier sende prøvemateriale til oss for følgende analyser:
Påvisning av Legionella antigen (LAG) utover Legionella pneumophila sg 1 (urin)
Analyse for påvisning av L. penumophila sg 1-15 og L. longbeachae antigen i urin med LAG negativ test. De fleste standard LAG tester påviser kun L. pneumophila sg 1. Urinprøve fra pasienter med sterk mistanke om/eller påvist Legionella-pneumoni men med negativ L. pnemophila sg 1 LAG test kan sendes inn til analyse. Merk rekvisisjonen med: «Sterk mistanke/påvist Legionella-pneumoni, Negativ LAG L.pn sg 1»
Bekreftende PCR L.pneumophila og L.spp (nedre luftveisprøver)
16S PCR for påvisning av L. pneumophila og L. species DNA. PCR-positive prøver dyrkes. Merk rekvisisjonen med: «Ønsker bekreftende PCR» samt resultat fra egen PCR
Utvidet Legionella species PCR (nedre luftveisprøver)
I prøvemateriale hvor det er påvist Legionella spp DNA utføres utvidet Legionella species PCR-analyse spesifikk for et utvalg klinisk relevante Legionella (non-pneumophila) species (L.micdadei, L.longbeachae, L.bozemanae og L.anisa). PCR-positive prøver dyrkes. Merk rekvisisjonen med: «L.spp DNA påvist, ønsker utvidet PCR»
Sekvensbasert typing (SBT) av L. pneumophila ved amplikonsekvensering (nedre luftveisprøver)
I tilfeller hvor L. pneumophila PCR-positiv prøve er dyrkningsnegativ vil sekvensbasert typing (SBT) direkte fra prøvematerialet vurderes.
Legionella species identifikasjon (bakterieisolat)
Legionellaisolater karakteriseres gjennom artsidentifisering med agglutinasjon, Maldi-TOF og helgenomsekvensering. Merk rekvisisjonen med «Ønsker Legionella species id»
Sekvensbasert typing (SBT) av L. pneumophila ved helgenomsekvensering (bakterieisolat)
Legionella pneumophila-isolat, alle serotyper, genotypes med sekvensbasert typing (SBT) basert på helgenomsekvensering. Merk rekvisisjonen med “Ønsker SBT fra prøvemateriale»
Utbruddsoppklaring/smittesporing (bakterieisolat)
I forbindelse med utbrudds- eller smitteoppklaring vil helgenomsekvenserte pasient- og miljøisolat sammenliknes vha bioinfomatiske analyser. Merk rekvisisjonen med «Smittesporing/utbruddsanalyse»
Legionella-antistoff (serum)
Legionella-antistoff påvisning er hovedsakelig aktuelt som del av en epidemiologisk undersøkelse i forbindelse med utbrudd. Serologi er lite nyttig i akuttfasen og bør alltid baseres på titerstigning i serumpar. Diagnosen Pontiac feber kan stilles serologisk, men dette er mest aktuelt i forbindelse med epidemiologisk undersøkelse ved utbrudd.
Resistensundersøkelse (bakterieisolat)
Resistenstesting har frem til nå kun vært utført i forskningssammenheng. I mai 2021 kom EUCAST med oppdaterte retningslinjer for resistensbestemmelse av Legionella pneumophila.
I mars 2022 ble det satt i gang en 2-årig studie i regi av ESGLI for å utvikle en standardisert metode for Legionella resistensbestemmelse. Avdelingen har vært med i valideringsprosessen av denne metoden og planlegger å innføre metoden når den er tilgjengelig.
- ELDSNet (The European Legionnaires’ Disease Surveillance Network) – Operational Contact Point (OCP) for mikrobiologi i Norge.
- ESGLI (ESCMID Study Group for Legionella Infections)
Nyttige linker
For smittevernrutiner ved påvisning av enkelttilfeller av legionellose eller ved mistanke om utbrudd, se Smittevernveilederen Folkehelseinstituttet (fhi.no)
Ved påviste tilfeller av legionærsyke eller utbrudd er det ønskelig å lokalisere smittekilde. Referanselaboratoriet gjør ulike sammenlignende bioinformatiske analyser av helgenomsekvens fra bakterieisolat fra kliniske isolat og isolat fra vann- og miljøprøver
Det kan også være aktuelt med analyser av Legionella-antistoff i serumprøver som del av en epidemiologisk undersøkelse i forbindelse med utbrudd.
Referanselaboratoriet utfører per nå ikke selv primærdiagnostikk av vann- og miljøprøver ved utredning av smittekilde. Slike prøver sendes til egnet miljølaboratorium for analyse. Ved oppvekst av Legionella bes miljølaboratoriet sende stammen til referanselaboratoriet slik at referanse-laboratoriet kan gjøre sekvensbasert typing av stammen og sammenligne med kliniske isolat.
Referanselaboratoriet holder oversikt over positive funn og lagrer pasient-relaterte legionella-isolat og annet referansemateriale i nasjonal stammebank for Legionella.
Mikrobiologiske laboratorier skal sende inn følgende til lagring i stammebanken:
- Isolat fra pasienter
- Isolat fra vann- og miljøprøver i forbindelse med smitteoppsporing rundt kliniske tilfeller
I tillegg ønsker vi å få tilsendt legionella-positivt prøvemateriale (urin, nedre luftveisprøver) til vår samling av referansemateriale.
Vi ønsker også å få tilsendt serumprøver fra personer som har testet positivt for legionella for å kunne opprettholde høy kompetanse på analyse av legionella antistoff.
Mer informasjon om hvordan ulike prøvematerialer kan sendes til oss finner du under innsending av prøvemateriale.
Medisinske mikrobiologiske laboratorier kan ved forespørsel på mail få tilsendt isolater til bruk i uttesting og validering/verifisering av nye metoder.
Kontakt
Ansvarlig Nasjonalt referanselaboratorium for Legionella
Anne Vatland Krøvel
e-post: anne.vatland.krovel@sus.no
tlf +47 92604914
Fokusområder
Prosjekter og samarbeid
- Legionella nye SUS - forekomst og effekt av forebyggende tiltak. Samarbeid mellom referanselaboratoriet, drift og smittevern
- L. longbeachae - an emerging pathogen in Europe. ESGLI-samarbeid med Sverige, Danmark, Finland og Skottland
- Legionella International Typing (LIT). Arbeidsgruppe for utvikling av et internasjonalt typing scheme for Legionella. Koordinert av CDC og Legionella EURL
- EU/EEA genmic surveillance for Legionnaires' disease. Pilot for uttesting av ECDC sitt Molecular Typing Tool. Ledet av ECDC
- Legionella AST-prosjektet. ESGLI-samarbeid om utvikling av standardisert metode for resistenstesting av L. pneumophila-isolat. Ledet av Brad Spiller ved Cardiff University, School of Medicine
Avsluttede prosjekt:
- Legionella i kommunale dusjanlegg- Undersøkelse av utbredelse, typer og virulens med tanke på risikostyring. Samarbeid med IRIS (International Research Institute of Stavanger), Stavanger kommune, Universitetet i Stavanger/SEROS og University of Michigan Medical School (Michele Swanson). Finansiert av Regionale Forskingsfond Vestlandet. Lenke til rapport (PDF), lenke til artikkel
- Legionella pneumophila og resistens mot antimikrobielle midler. Samarbeid med Haukeland Universitetssykehus
Publikasjoner og konferanser
Publikasjonsliste
Poster: Increased number of infections caused by Legionella longbeachae during 2024 in Sweden, Finland, Norway, Denmark and Scotland. Schönning C., Touriki E., Brynedal Öckinger J., Iversen A., Lindsay D., Mentula S., Airaksinen P., Miller T., Savonen E., Ikonen J., Niittynen M., Eves C., Sørensen J.S., Kjelsø C., Epstein H.K., Uldum S A., Krøvel A.V., Lund H.M., Wasserstrom L. ESCMID Global, 11-15 April 2025, Wien, Østerrike
Poster: Improving the first line diagnostics of Legionnaires’ disease using the LIAISON Legionella Urinary Ag kit (2024). Krøvel A.V., Obreque M. E.B., Syre H., Romstad M.R. and Löhr I.H. The 8th ESGLI meeting 24-25/10 2024. Dresden, Tyskland
Poster: ONTmompS - a tool for in silico sequence-based typing (SBT) of Legionella pneumophila completed genomes (2023). Krøvel A.V., Hetland M.A.K,, Bjørheim A.S., Bernhoff E., Løhr I.H. The 7th ESGLI meeting 23-24/10. Kreta.
Poster: Nanopore sequencing as a solution to the mompS challenge in L. pneumophila SBT from short-read data (2022). Krøvel A.V,. Bernhoff E., Soma M.A., Hetland M.A.K., Romstad M.R. and Löhr I.H. The 10th International conference on Legionella, Japan, September 20-24.
Legionella pneumophila in Municipal Shower Systems in Stavanger, Norway; a Longitudinal Surveillance Study using Whole Genome Sequencing in Risk Management (2022). Krøvel A.V., Bernhoff E., Austerheim E., Soma M.A., Romstad M.R. and Löhr I.H. Microorganisms; 10 (3);536.
Susceptibility of Legionella pneumophila to antimicrobial agents and the presence of the efflux pump LpeAB (2019). Natås O.B., Brekken A.L., Bernhoff E., Hetland M.A.K., Löhr I.H and Lindemann P.C. J Antimicrob Chemother. Jun 1;74(6):1545-1550. doi: 10.1093/jac/dkz081.
Poster: Legionella pneumophila in municipal shower systems in Stavanger, Norway; a longitudinal study of incidences and types (2015). Krøvel A.V., Bernhoff, E., Rangnes, K and Natås, O.B. 3rd ESGLI meeting, London, UK, September 16-17th.
Ansvarlig Nasjonalt referanselaboratorium for legionella
Ansvarlig overlege legionella
e-post: monica.regine.romstad@sus.no